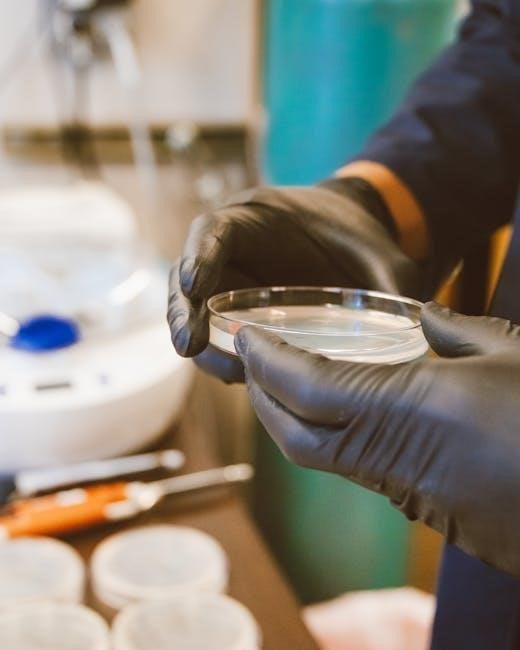

Disc Analysis Test PDF: A Comprehensive Guide
Navigating the world of personality assessments can be complex, and finding reliable resources is key. This guide focuses on DISC analysis, offering insights and access to PDF resources.
Understanding your behavioral style is crucial for personal and professional growth, and this guide will help you!
What is a Disc Analysis Test?
DISC assessment is a personal evaluation tool based on the work of William Moulton Marston, designed to analyze behavioral traits and communication styles. It doesn’t measure intelligence, aptitude, or skills, but rather focuses on how people behave and respond in various situations. The acronym DISC stands for Dominance, Influence, Steadiness, and Conscientiousness – four primary personality traits used to categorize individual behavioral patterns.

A DISC analysis test typically presents a series of multiple-choice questions or forced-choice word associations. Respondents select the option that best reflects their natural reactions and preferences, not necessarily how they think they should behave. The results are then compiled to generate a personalized profile, illustrating the individual’s tendencies across the four DISC factors.

DISC profiles are often presented graphically, showing the relative strength of each factor. These profiles are valuable for self-awareness, team building, and improving interpersonal communication. Many DISC assessments are available online, some free and others requiring a fee for detailed reports and analysis. Finding a DISC analysis test PDF often means accessing sample reports or introductory materials, rather than the full assessment itself.
Purpose of Disc Analysis
The core purpose of DISC analysis is to foster self-understanding and improve interpersonal effectiveness. By identifying an individual’s dominant behavioral traits, DISC provides valuable insights into their strengths, weaknesses, motivations, and communication preferences. This self-awareness is foundational for personal growth and development.
In professional settings, DISC analysis serves multiple crucial functions. It enhances team dynamics by helping members understand each other’s working styles, leading to improved collaboration and reduced conflict. It’s also a powerful tool for leadership development, enabling leaders to adapt their approach to effectively motivate and manage diverse teams.
Furthermore, DISC aids in communication improvement. Recognizing how others process information and respond to different communication styles allows for more targeted and impactful interactions. Accessing a DISC analysis test PDF can provide introductory examples of how these principles are applied. Ultimately, the goal is to leverage DISC insights to build stronger relationships and achieve better outcomes in both personal and professional life.
The DISC Model Explained
The DISC model is a behavioral assessment tool based on the work of William Moulton Marston. It centers around four primary personality traits: Dominance, Influence, Steadiness, and Conscientiousness. These aren’t rigid categories, but rather represent tendencies along a spectrum of observable behaviors.
Each trait reflects a different way individuals respond to challenges and interact with their environment. Dominance focuses on achieving results, Influence emphasizes relationships and persuasion, Steadiness prioritizes cooperation and consistency, and Conscientiousness values accuracy and quality. A DISC analysis test PDF often illustrates these traits graphically.
The model doesn’t label people, but instead provides a framework for understanding how people behave, not why. It’s important to remember that everyone possesses all four traits to varying degrees. The DISC assessment identifies the most dominant traits, revealing an individual’s typical behavioral style. Understanding this model is crucial for interpreting DISC profile reports and applying the insights effectively.
The Four DISC Factors
The core of the DISC assessment lies in evaluating four key behavioral factors: Dominance (D), Influence (I), Steadiness (S), and Conscientiousness (C). These factors represent different ways individuals approach challenges, interact with others, and respond to their environment. A comprehensive DISC analysis test PDF will detail each factor.
Each factor isn’t simply a personality type, but a continuum of observable behaviors. Individuals exhibit varying degrees of each trait, creating a unique behavioral profile. Understanding these factors allows for better self-awareness and improved interpersonal communication. The DISC model provides a common language for discussing behavioral preferences.
Analyzing these four factors, often presented visually in a DISC graph within a PDF report, reveals patterns in an individual’s responses. This insight is valuable for team building, leadership development, and conflict resolution. Recognizing these factors is the first step towards leveraging the power of DISC assessment.
Dominance (D) – Characteristics and Behaviors
Individuals scoring high in Dominance (D) are typically direct, decisive, and results-oriented. A DISC analysis test PDF will highlight this tendency. They prioritize achieving goals and often take charge in situations, displaying confidence and a willingness to challenge the status quo. These individuals are motivated by power and control, and thrive in competitive environments.
Key characteristics include a focus on immediate results, a preference for independence, and a tendency to be assertive. They can sometimes be perceived as demanding or impatient, but their drive and determination are often valuable assets. A detailed DISC report PDF will outline potential strengths and weaknesses.
In the workplace, ‘D’ styles excel in leadership roles requiring quick decision-making. They are comfortable with risk and enjoy tackling complex problems. Understanding these traits, as detailed in a DISC profile PDF, fosters effective communication and collaboration with dominant personalities.
Influence (I) – Characteristics and Behaviors
Those who score high in Influence (I) on a DISC assessment are typically enthusiastic, optimistic, and persuasive. A comprehensive DISC analysis test PDF will clearly demonstrate this behavioral tendency. They thrive in social settings, building rapport easily and enjoying collaboration. Individuals with a strong ‘I’ style are motivated by social recognition and positive relationships.
Key characteristics include excellent communication skills, a natural ability to inspire others, and a preference for teamwork. They are often creative and enjoy brainstorming new ideas. However, they can sometimes be perceived as disorganized or overly emotional. A detailed DISC report PDF will provide a nuanced understanding of these traits.
In professional settings, ‘I’ styles excel in roles requiring strong interpersonal skills, such as sales, marketing, or public relations. They are adept at building networks and fostering positive relationships. Examining a DISC profile PDF helps understand how to best leverage their strengths.
Steadiness (S) – Characteristics and Behaviors

Individuals scoring high in Steadiness (S) on a DISC assessment are known for their calm, patient, and reliable nature. A detailed DISC analysis test PDF will highlight this consistent behavioral pattern. They value stability, predictability, and harmonious relationships, preferring a steady pace and avoiding conflict whenever possible. These individuals are excellent listeners and demonstrate strong loyalty.
Key characteristics include a dependable work ethic, a preference for established routines, and a supportive attitude towards colleagues. They excel at providing consistent, quality work and are often seen as team players. However, they may sometimes resist change or struggle with assertiveness. A comprehensive DISC report PDF will offer insights into these nuances.
Professionally, ‘S’ styles thrive in roles requiring patience, attention to detail, and a collaborative spirit, such as administrative support, customer service, or operations. Understanding their profile, as detailed in a DISC assessment PDF, allows for effective team integration.

Conscientiousness (C) – Characteristics and Behaviors
Those exhibiting high Conscientiousness (C) in a DISC profile are defined by their precision, analytical skills, and dedication to quality. A thorough DISC analysis test PDF will reveal a focus on accuracy and adherence to standards. Individuals with a ‘C’ style prioritize logic, facts, and thoroughness in all endeavors, often displaying a reserved and cautious demeanor.
Key traits include a meticulous approach to work, a strong sense of responsibility, and a commitment to continuous improvement. They excel at problem-solving, data analysis, and ensuring compliance. However, they can sometimes be perceived as overly critical or perfectionistic. A detailed DISC report PDF will illuminate these potential challenges.
Professionally, ‘C’ styles flourish in roles demanding precision, analytical thinking, and attention to detail, such as accounting, engineering, or research. Understanding their behavioral tendencies, as outlined in a DISC assessment PDF, is vital for effective leadership and team dynamics.
How DISC Assessments are Administered
DISC assessments are typically administered online, offering convenience and efficient data collection. Most providers utilize a questionnaire format, presenting participants with a series of forced-choice questions. These questions ask individuals to select words or phrases that best describe their natural behaviors and preferences. A comprehensive DISC analysis test PDF often details the administration process.
The assessment itself usually takes around 15-30 minutes to complete. Upon completion, the responses are scored and analyzed to generate a personalized DISC profile report. Some assessments are ‘untimed’, allowing ample consideration, while others have time constraints to encourage instinctive responses. Accessing a sample DISC report PDF can illustrate the output format.
Various platforms offer administration options, including self-assessments, facilitator-led sessions, and team reports. The choice depends on the intended application – individual development, team building, or organizational analysis; Many DISC providers offer downloadable guides in PDF format explaining the administration process.
Types of DISC Assessments Available
DISC assessments come in various forms, catering to diverse needs and budgets. Classic DISC profiles focus on the four primary factors – Dominance, Influence, Steadiness, and Conscientiousness – providing a foundational understanding of behavioral tendencies. Many providers offer these as downloadable PDF reports.

Extended DISC assessments delve deeper, incorporating additional factors and nuances to offer a more comprehensive profile. These often include scales for motivation, emotional intelligence, and stress management. Finding a detailed comparison PDF can help differentiate these options.
There are also team DISC assessments designed to analyze group dynamics and communication patterns. These reports highlight strengths, potential conflicts, and strategies for improved collaboration. Some vendors provide facilitator guides in PDF format. Furthermore, 360-degree DISC assessments gather feedback from peers, supervisors, and subordinates for a holistic view. Exploring sample reports in PDF format is recommended before choosing an assessment.
Free DISC Assessments Online
Numerous websites offer free DISC assessments, providing a convenient entry point for exploring the model. However, it’s crucial to understand the limitations of these free versions. Often, they are abbreviated, offering a basic overview rather than a detailed, personalized report. Many present results immediately on the webpage, but some offer a downloadable PDF summary.

While useful for initial self-discovery, free assessments typically lack the depth and validation of paid options. They may not include comprehensive scoring, behavioral analysis, or personalized recommendations. Be cautious of sites requesting excessive personal information in exchange for a free DISC profile. Always review the provider’s privacy policy.
Several reputable providers offer limited free assessments as a “teaser” for their paid services. These can be a good starting point, but remember the full value lies in the more in-depth reports. Searching for “free DISC assessment PDF” may yield some basic downloadable questionnaires, but verify their source and validity.
Paid DISC Assessments and Reports
Investing in a paid DISC assessment unlocks a significantly more detailed and accurate understanding of your behavioral style. These assessments typically involve a more extensive questionnaire and are often administered by certified DISC professionals. The resulting reports are comprehensive, providing in-depth analysis of your DISC profile, including strengths, weaknesses, communication preferences, and potential areas for development.
Paid assessments often come in PDF format, allowing for easy storage and repeated review. They frequently include personalized interpretations, action plans, and comparative reports to understand how you interact with others. Different providers offer varying levels of detail and additional features, such as team reports and leadership modules.
Costs can range from around $50 to several hundred dollars, depending on the provider and the scope of the report. While a larger investment, the enhanced insights and actionable strategies offered by paid DISC assessments can be invaluable for personal and professional growth. Look for assessments validated by research and offered by reputable organizations.
Understanding Your DISC Profile Report
Your DISC profile report, often delivered as a PDF document, is more than just a collection of letters; it’s a roadmap to understanding your behavioral tendencies. The report will detail your primary DISC style – the factor you most naturally exhibit – and the blend of the other factors influencing your behavior. Don’t focus solely on the dominant trait; the nuances within the combination are crucial.

Reports typically include a graphical representation of your scores, making it easy to visualize your profile. Pay attention to the narrative accompanying the graph, as it explains how your style manifests in various situations. Look for sections detailing your strengths, areas for potential development, and common stressors.
Understanding your “dots” on the graph – representing your scores for each factor – is key. Higher dots indicate a stronger inclination towards that style. Remember, no style is “better” than another; each has unique advantages. Use your report as a tool for self-awareness and improved interpersonal effectiveness.
Interpreting DISC Graphs and Charts
DISC graphs and charts, frequently found within PDF reports, visually represent your behavioral tendencies. Typically, these charts utilize a four-quadrant model, with each quadrant corresponding to a DISC factor: Dominance, Influence, Steadiness, and Conscientiousness. Your position on the graph isn’t absolute; it indicates the degree to which you exhibit each style.
The closer your dot is to a quadrant, the stronger that particular style is in your behavioral profile. Lines connecting your dots create a shape, revealing your overall behavioral blend. This shape isn’t about categorization, but about understanding your unique combination of traits.

Pay attention to opposing styles. For example, a high D (Dominance) score often correlates with a lower S (Steadiness) score, and vice versa. These relationships provide valuable insights into your natural preferences and potential challenges. Remember to consider the entire picture, not just individual scores, for a comprehensive interpretation.
DISC and Team Building
DISC analysis proves invaluable for enhancing team dynamics, often detailed within comprehensive PDF reports. Understanding each team member’s DISC profile fosters empathy and improves communication. Teams comprised of diverse DISC styles often achieve greater success, leveraging a wider range of skills and perspectives.
By recognizing individual behavioral tendencies, teams can proactively address potential conflicts. For instance, a highly Dominant team member might benefit from collaborating with a more Steadiness-oriented colleague to ensure thoroughness. Conversely, a Conscientious member could gain confidence from a Influential teammate’s enthusiasm.
DISC facilitates more effective delegation and task assignment. Matching tasks to individual strengths maximizes productivity and job satisfaction. Team building workshops utilizing DISC assessments can create a more cohesive and high-performing unit, improving overall collaboration and results.
Using DISC in the Workplace
DISC assessments, often available as detailed PDF reports, offer significant benefits within professional settings. Implementing DISC insights can revolutionize hiring practices, ensuring a better cultural fit and predicting job performance. Understanding employee behavioral styles allows managers to tailor their leadership approach for optimal results.
DISC profiles can illuminate communication preferences, minimizing misunderstandings and fostering stronger working relationships. For example, knowing an employee is primarily Conscientious suggests a preference for detailed, data-driven communication. Conversely, an Influential employee thrives on enthusiastic and collaborative interactions.
Furthermore, DISC aids in conflict resolution by identifying the underlying behavioral drivers of disagreements. It provides a framework for constructive dialogue and finding mutually agreeable solutions. Utilizing DISC in the workplace cultivates a more productive, harmonious, and engaged workforce, ultimately boosting organizational success.
DISC for Leadership Development
DISC assessment PDF reports are invaluable tools for leadership development, providing self-awareness and actionable insights. Leaders who understand their own DISC profile can leverage their strengths and mitigate weaknesses, becoming more effective and adaptable.
A leader with high Dominance, for instance, might learn to temper their directness to foster greater collaboration. Conversely, a leader high in Steadiness could benefit from developing more assertive communication skills. DISC highlights blind spots and areas for growth, facilitating targeted development plans.
Moreover, understanding the DISC profiles of team members allows leaders to tailor their coaching and mentoring approaches. Effective leaders inspire and motivate by speaking to individual needs and preferences. DISC empowers leaders to build stronger relationships, foster trust, and unlock the full potential of their teams, ultimately driving organizational success.
DISC and Communication Styles
DISC assessment PDF reports reveal how individuals prefer to communicate, offering crucial insights for building rapport and avoiding misunderstandings. Each DISC style has distinct communication preferences; recognizing these differences is paramount for effective interaction.
Those with high Dominance tend to be direct and results-oriented in their communication, valuing brevity and decisiveness. Individuals high in Influence are typically enthusiastic and persuasive, focusing on building relationships. Steadiness-oriented communicators prioritize calmness and collaboration, preferring a patient and supportive approach.
Conversely, those with high Conscientiousness favor precision and accuracy, often communicating through detailed analysis and careful consideration. Understanding these styles allows individuals to adapt their communication to resonate with others, fostering clearer understanding and stronger connections. DISC promotes empathy and minimizes friction in both personal and professional settings.
Improving Communication Based on DISC Profiles
DISC assessment PDF reports aren’t just about identifying styles; they’re tools for enhancing communication. Tailoring your approach based on another’s DISC profile dramatically improves understanding and reduces conflict. For example, when communicating with a high ‘D’ style, be direct and focus on results, avoiding excessive detail;
With ‘I’ styles, prioritize building rapport and showcasing enthusiasm. Allow them to express themselves and focus on the positive aspects of your message. For ‘S’ styles, demonstrate patience and create a supportive environment, avoiding abruptness or pressure. When interacting with ‘C’ styles, provide thorough information and demonstrate accuracy.
By adapting your communication to match their preferences, you build trust and foster stronger relationships. DISC encourages active listening and mindful messaging, leading to more productive conversations and collaborative outcomes. Utilizing DISC insights transforms interactions from potential clashes into opportunities for connection.
DISC and Conflict Resolution
DISC assessment PDF reports offer valuable insights into how individuals typically respond to conflict, providing a framework for more effective resolution. Understanding someone’s DISC style can illuminate the root cause of disagreements and predict their likely reactions. High ‘D’ styles may become assertive and direct, while ‘I’ styles might become defensive or emotional.
‘S’ styles tend to avoid conflict, prioritizing harmony, and may withdraw or become passive-aggressive. ‘C’ styles will analyze the situation logically, seeking accuracy and potentially becoming critical. Recognizing these tendencies allows you to tailor your approach;
For instance, with a ‘D’ style, focus on facts and solutions, avoiding emotional appeals. With an ‘S’ style, offer reassurance and a calm environment. A ‘C’ style appreciates detailed explanations and logical reasoning. DISC promotes empathy and helps de-escalate tensions by fostering understanding of differing behavioral norms, leading to mutually agreeable outcomes.
Finding DISC Analysis Test PDFs
Locating reliable DISC analysis test PDF resources requires careful navigation. Many websites offer free introductory assessments, often providing a basic DISC profile report in PDF format upon completion. However, these are typically limited in scope and depth. Be cautious of sites requesting excessive personal information in exchange for a free report.
More comprehensive DISC assessments and detailed reports, often exceeding 20 pages, are usually available for purchase. These premium PDF reports offer in-depth analysis, including behavioral tendencies, communication styles, and potential areas for development.
Professional DISC certification programs frequently provide participants with access to a library of PDF resources, including assessment tools and interpretation guides. Searching for “DISC assessment sample report PDF” can yield examples, but remember these may not be full reports. Always verify the source’s credibility before downloading any PDF document.
Reliability and Validity of DISC Assessments
DISC assessments, while popular, face scrutiny regarding their scientific rigor. Reliability refers to the consistency of results – a reliable test should yield similar profiles upon repeated administrations. Validity assesses whether the test measures what it intends to measure – behavioral styles. Establishing strong validity proves challenging due to the subjective nature of personality.
Early DISC models lacked extensive empirical validation. Modern, validated versions demonstrate acceptable test-retest reliability, meaning scores are relatively stable over time. However, concerns remain about social desirability bias, where respondents answer in a way they perceive as favorable.
It’s crucial to remember DISC isn’t a diagnostic tool; it’s a behavioral assessment. A PDF report should be interpreted as a guide, not a definitive label. The value lies in self-awareness and improved interpersonal understanding, not predicting absolute behaviors. Responsible use and acknowledging limitations are paramount.
Limitations of DISC Assessments
DISC assessments, despite their widespread use, aren’t without limitations. A primary concern is oversimplification of complex human behavior. Reducing personality to four dimensions can overlook nuances and individual variations. Relying solely on a DISC profile for critical decisions – like hiring – is strongly discouraged.
The assessments are susceptible to situational influences; behavior can shift based on context, which a static profile may not capture. Self-reporting introduces subjectivity, potentially leading to inaccurate results if individuals lack self-awareness or answer dishonestly. A PDF report provides a snapshot, not a complete picture.
Furthermore, DISC doesn’t account for cognitive abilities, values, or motivations – crucial aspects of personality. It’s best used as a starting point for discussion and development, not a definitive categorization. Understanding these limitations ensures responsible interpretation and application of DISC insights.




Leave a Reply
You must be logged in to post a comment.